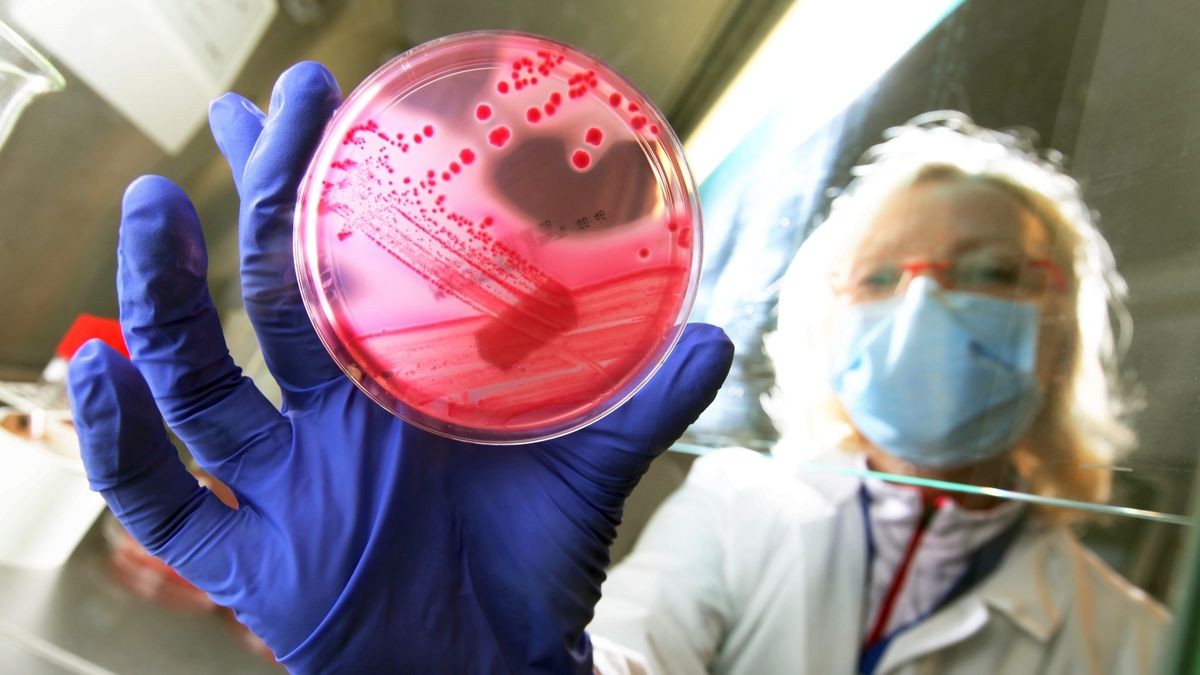
In den Labors des UKE wurden Proben untersucht In den Labors des UKE wurden Proben untersucht

Hamburg. 2011 hielt die Epidemie Hamburg in Atem. Blick zurück auf eine Zeit im Ausnahmezustand, in der 670 Menschen erkrankt waren.
Manche Ereignisse brennen sich tief in das Gedächtnis ein, Manchmal kann man sich noch Jahre später an die Abläufe erinnern, als wäre es gestern gewesen. Dazu gehört sicherlich auch die EHEC-Epidemie, die Hamburg 2011 wochenlang in Atem hielt. Im Mai wurden die ersten Erkrankungen gemeldet. Die Infizierten litten unter Erbrechen und blutigen Durchfällen. In den Krankenhäusern lagen viele schwerkranke Patienten, bei denen es zu einer gefürchteten Komplikation der Infektion, dem HUS (Hämolytisch-Urämisches Syndrom), gekommen war, das mit akutem Nierenversagten und Störungen im Gehirn einherging.
Nach den ersten Erkrankungen begann die fieberhafte Suche nach der Infektionsursache. Der EHEC-Erreger war schnell identifiziert, doch wo lag die Quelle der Infektion? Schnell gerieten Tomaten, Gurken und Blattsalate in Verdacht, zu Unrecht, wie sich später herausstellte. Letztendlich kamen die Behörden zu dem Schluss, dass höchstwahrscheinlich aus Ägypten importierte Bockshornkleesamen mit den Bakterien verseucht waren. Nach Ende der Epidemie im Juli zog das Berliner Robert-Koch-Institut eine traurige Bilanz: 2987 Patienten waren an einem Magen-Darm Infekt durch den Erreger erkrankt, 855 an der schweren Komplikation HUS, 53 Menschen starben an den Folgen von EHEC und HUS.

Allein in Hamburg wurden 670 Patientinnen und Patienten behandelt, die entweder an EHEC (493) erkrankt waren oder ein HUS (177) entwickelt hatten. Zu diesen Patienten gehörte auch Brigitte Weden. Wenn sie sich an damals erinnert, weiß sie noch, dass sie sich tagelang nicht wohlfühlte. Ständig kamen in den Nachrichten neue Schreckensmeldungen über den EHEC-Erreger. Als sie dann bei sich Blut im Stuhl entdeckte, war sie sicher: Das ist EHEC und fuhr ins Universitätsklinikum Eppendorf. Dort war bereits eine Notfallstation für diese Patienten eingerichtet worden. Sie wurde untersucht und wieder nach Hause geschickt, auch zwei Tage später nach einem erneuten Besuch wurde sie wieder entlassen.
Doch zu Hause ging es der heute 76-Jährigen immer schlechter. Als sie nicht mehr richtig sprechen konnte, rief ihre Tochter den Rettungswagen, der sie ins UKE brachte. Brigitte Weden litt vor allem unter Störungen des Gehirns. „Ich hatte Halluzinationen, und bei der neurologischen Untersuchung konnte ich nicht mehr schreiben und nicht mehr rechnen. Nach drei Tagen waren diese Symptome wieder verschwunden. Bei der nächsten neurologischen Untersuchung konnte ich alles wieder, sogar auf Englisch antworten“, erzählt die ehemalige Sekretärin. 14 Tage blieb Brigitte Weden im Krankenhaus. Aber ein Vierteljahr hat sie gebraucht, um sich davon zu erholen. „Ich habe durch die Krankheit einen Schlag mitgekriegt.“ Zwei Jahre danach sei Bluthochdruck dazugekommen, und an schlechten Tagen habe sie Probleme mit dem Sprechen.
Das UKE, das damals im Zentrum der Epidemie stand, weil dort auch die meisten HUS-Patienten behandelt wurden, hat diese Patienten die ersten drei Jahre nach der Infektion nachuntersucht. „Von den 138 HUS-Patienten, die hier im UKE behandelt wurden, haben 75 bis 80 an den Nachuntersuchungen teilgenommen. Davon hatten fünf bis acht Prozent drei Jahre nach der Infektion noch einen Bluthochdruck und einen leichten Nierenschaden. Und es gibt einzelne Patienten, die leichte neurologische Störungen wie Erinnerungslücken haben“, sagt der Nierenspezialist Prof. Rolf Stahl, Direktor der III. Medizinischen Klinik im UKE und damals verantwortlich für die Behandlung der HUS-Patienten. Auch für ihn und seine Kollegen war es eine schwere Zeit.
„Wir hatten hier zwischen 70 und 80 junge Menschen, die plötzlich ihre Nierenfunktion verloren haben, die schwerste neurologische Störungen bekommen haben. Wir konnten nicht einfach zuschauen und abwarten.“
In dieser Situation traf er die Entscheidung, die Patienten mit dem neuen Antikörper Eculizumab zu behandeln, der in den Entzündungsprozess eingreift. Bis dahin gab es dazu nur eine Studie, in der beschrieben wurde, dass drei Kinder damit erfolgreich behandelt worden waren, die an HUS erkrankt waren. Leicht gemacht hatte Stahl sich diese Entscheidung nicht. „Ich habe einige Nächte nicht geschlafen. Aber wir wussten , dass dieses Medikament kaum Nebenwirkungen hat und haben es dann bei allen Schwerkranken eingesetzt, insbesondere bei den Patienten mit Störungen des Gehirns“, sagt Stahl.
Ob das Medikament wirklich geholfen hat, ist bis heute unklar. „Wir haben immer noch den Eindruck, dass das Eculizumab zu einer schnelleren Verbesserung geführt hat. Wir können das aber nicht im klassischen Sinne einer medizinischen Studie belegen, weil wir keinen Vergleich haben mit Patienten, die nicht damit behandelt worden sind. Deshalb wird das eine offene Frage bleiben“, sagt Stahl.
Er denkt aber auch, dass man das Medikament auch ohne wissenschaftlichen Nachweis wieder einsetzen würde, wenn erneut eine EHEC-Epidemie ausbräche, was nicht auszuschließen sei. „Denn EHEC-Infektionen gibt es immer wieder, und bei allen diesen Bakterien besteht das Risiko einer HUS-Komplikation.“
Trotzdem war die Epidemie von 2011 die größte und schwerste EHEC-Epidemie, die es je gab, für Stahl persönlich ein Katastrophenerlebnis, das er so noch nie erlebt hatte: „Ich hatte sehr viele Sorgen um die Patienten. Für manche Situationen hatten wir keine etablierte Therapie, und dann sind wir in eine experimentelle Therapie eingestiegen, die ich zu verantworten hatte. Das waren meine schwierigsten Tage in der Medizin.“
Für Patienten und Ärzte in den Kliniken waren es Wochen voller Bangen und Hoffen, für die Bevölkerung eine Zeit großer Verunsicherung – und für viele Gemüsebauern der Beginn einer schweren wirtschaftlichen Krise. Viele von ihnen bieten ihre Produkte auf dem Hamburger Großmarkt an und waren nach Angaben des Bauernverbandes Hamburg vom ersten Tag der Epidemie an betroffen, weil sie ihre Waren nicht mehr verkaufen durften. Die ersten Gurken, die geerntet wurden, konnten schon nicht mehr verkauft werden, dann auch keine Blattsalate mehr. Beide Gemüsearten sind die wichtigsten Kulturen im Gemüsebau in Hamburg und Umgebung. „Durch die EHEC-Epidemie sind immense Verluste aufgetreten, die ein riesiges Loch in die Kassen gerissen haben. Das ging bei vielen Gemüsebauern an die Substanz. Später wurde etwas von der Europäischen Union erstattet, aber dadurch wurden die Verluste bei Weitem nicht gedeckt,“ sagt Dr. Carsten Bargmann, Geschäftsführer des Bauernverbandes Hamburg. Zwei Jahre habe es gedauert, bis sich die Unternehmen, darunter auch viele Familienbetriebe, von diesen Verlusten erholt hätten.

Ein Gemüseproduzent aus Spanien verklagte die Stadt Hamburg auf Schadenersatz. Das Landgericht Hamburg gab dem Unternehmen recht und legte in einem Grundsatzurteil im vergangenen Jahr fest, dass die Hansestadt dem spanischen Unternehmen Frunet Schadenersatz zahlen muss, weil sie während der Epidemie voreilig vor dem Verzehr von EHEC-belasteten Gurken aus Spanien gewarnt hatte. Daraufhin kündigte Gesundheitssenatorin Cornelia Prüfer-Storcks an, gegen das Urteil in Berufung zu gehen. Zum aktuellen Stand teilt die Gesundheitsbehörde auf Nachfrage mit, dass sie gegen das Urteil in Berufung gegangen ist und dass das Verfahren laufe.


